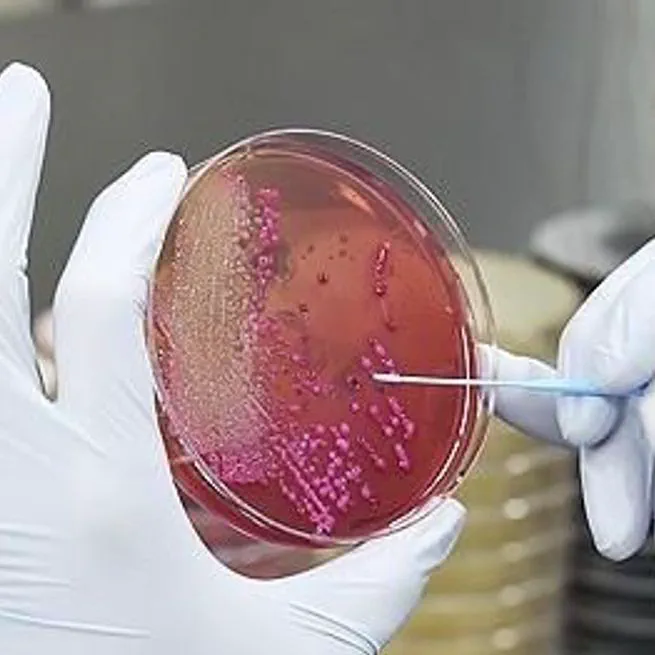
횡성군, 식중독 예방 만전…맞춤형 위생 컨설팅·수거검사

게임 협단체, '게임=질병' 성남시에 공개 사과 요구
6월 18, 2025
![[칼럼] 현대인의 영원한 단짝 카페인, 여드름 피부에 미치는 영향은?](/project/%EC%B9%BC%EB%9F%BC-%ED%98%84%EB%8C%80%EC%9D%B8%EC%9D%98-%EC%98%81%EC%9B%90%ED%95%9C-%EB%8B%A8%EC%A7%9D-%EC%B9%B4%ED%8E%98%EC%9D%B8-%EC%97%AC%EB%93%9C%EB%A6%84-%ED%94%BC%EB%B6%80%EC%97%90-%EB%AF%B8%EC%B9%98%EB%8A%94-%EC%98%81%ED%96%A5%EC%9D%80/featured_hu18011459830476208350.webp)
[칼럼] 현대인의 영원한 단짝 카페인, 여드름 피부에 미치는 영향은?
6월 18, 2025

한 스푼 가득 담아 꿀꺽 삼키는 '올리브오일', 건강에 최악
6월 17, 2025

전역 후 13kg 감량? BTS 뷔의 다이어트법
6월 17, 2025

뜨거운 여름밤, 시원한 맥주 한 잔... 건강에는 괜찮을까?
6월 17, 2025

다이어트 성공은 '아침'이 결정…하루를 건강하게 시작하는 방법
6월 17, 2025

긁지 말고 바르세요, 민감성 피부 탈출기
6월 17, 2025

20분이면 성형부터 다이어트까지 가능하다고? 한혜진과 혜리, 나나가 빠진 한방 뷰티 소개
6월 17, 2025
횡성군, 식중독 예방 만전…맞춤형 위생 컨설팅·수거검사
6월 16, 2025

스트레스솔루션, 日 월드넷과 협약… 현지 디지털 멘탈케어 시장 진출 본격화
6월 16, 2025